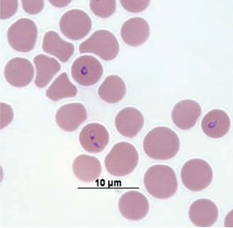

بقلم : الدكتورة / جيهان محمد سيد
باحث أول طفيليات – معهد بحوث الصحة الحيوانية – معمل أسيوط
الماشية تمثل ركيزة أساسية في الإقتصاد المصري ، فهى الثروة الحيوانية حيث تدعم الإقتصاد لتوفير الحليب واللحوم والجلود وكذلك استخدامها فى بعض الأعمال الزراعية.
الماشية
- البابيزيا هي طفيليات أولية توجد داخل كرات الدم الحمراء من شعبة Apicomplexa ، رتبة Piroplasmida ، عائلة Babesiadae.
- تصيب البابيزيا العديد من الحيوانات مثل الماشية والخيول والأغنام والماعز والخنازير والقطط وكذلك الحيوانات البرية ، وأحيانا الإنسان.
- داء البابيزيا البقري يطلق عليه أيضا اسم داء البيروبلازما وحمى تكساس وحمى المياه الحمراء وحمى الطحال.
مسببات المرض في الماشية
- أكثر أنواع البابيزيا اصابة للأبقارهى: بابيزيا بوفيس ) (Babesia bovis، بابيزيا بايجيمينا (Babesia bigemina) ،بابيزيا دايفيرجينز (Babesia divegens)
- bovis ، B. bigemina هي الأنواع المنتشرة حيث أن B. bovis تعتبرأكثر ضراوة من B. bigemina.
انتقال داء البابيزيا في الحيوانات:
- داء البابيزيا هو مرض قاتل ينتقل إلى الماشية عن طريق القراد أحادى العائلRhipicephalus (Boophilus) spp ticks المنتشرة في المناطق الإستوائية وشبه الإستوائية حيث ينقل كلا من B. bigemina و B. bovis ويصيب الأبقار والجاموس ويؤثر على صناعة الماشية بشكل كبير حيث تواجه خسائر اقتصادية فادحة.
- تنتقل أنواع البابيزيا فى القراد عن طريق المبيض مما يشير إلى استمرار الإصابة بالقراد لعدة أجيال.
- يمكن أن تنتقل البابيزيا بسهولة تجريبيا عن طريق تلقيح الدم ،وقد ثبت انتقالها عبر المشيمة في الماشية .
- كما تنتقل البابيزيا ميكانيكيا عن طريق الإبر والمحاقن المصابة ونقل الدم والأدوات الجراحية.
- عوامل تحديد خطر الإصابة بالأمراض السريرية في الماشية في المناطق الموبوءة :
1- تتمتع العجول بمستوى من المناعة (مرتبط بالأجسام المضادة المشتقة من اللبأ والعوامل الخاصة بالعمر) يستمر لمدة ~ 6-8 أشهر ، في حين أن الأكبر سنا التي ليس لديها مناعة عرضة للإصابة بالمرض .
2- الحيوانات التي تتعافى من عدوى البابيزيا تحمل أجسام مضادة بشكل عام لمقاومة تكرار الإصابة لفترة محددة طوال فترة الإنتاج وتعتمد على سلالات الأبقار ومدى
انتشار القراد فإذا تعرضت للقراد فسوف تكون عرضة للإصابة.
انتشار داء البابيزيا:
- المرض له أسوأ الآثار في صناعة الثروة الحيوانية من حيث التأثير على الحيوانات البالغة عند الإنتاج بدلا من الصغار ، مما يؤدي إلى الوفاة.
- يشكل هذا المرض أيضا عائقا أمام زيادة إنتاجية الماشية المحلية بسبب ارتفاع معدل الوفيات، وتحديدا الأبقار الحلوب التي يتم استيرادها من المناطق الخالية من البابيزيا.
- يحافظ الإتصال المتكرر مع مسببات الأمراض على المناعة ونسبة الحالات السريرية منخفضة في المناطق الموبوءة ، وفي الغالب تتأثرالحيوانات التي تعاني من نقص المناعة والتي تم إدخالها حديثا .

`
دورة حياة البابيزيا:
ينتقل المرض بين الأبقار من خلال القراد الناقل و يصبح القراد حاملًا لطفيل البابيزيا عندما يتغذى على دم أبقار مصابة، يحدث اقتران الخلايا المشيجية في أمعاء القراد متبوعا بالتكاثر والهجرة إلى الأنسجة المختلفة مثل الغدد اللعابية.علاوة على ذلك ، يحدث التطور المستمر في الغدد اللعابية. قد يحدث انتقال العدوى عبر المبيض في هذه المرحلة.
موضوعات هامة
ميناء دمياط: تستقبل 9019 طن ذرة و16240 طن قمح خلال الـ 24 ساعة الماضية
الإحصاء: ارتفاع واردات مصر من فول الصويا فى أغسطس الماضي نحو 220 مليون دولار
“الزراعة” تصدر 429 ترخيص تشغيل أنشطة إنتاج حيواني وداجني و343 تسجيلة أعلاف
عقود الذرة والصويا والقمح تنخفض بأكثر من 2.5% قبيل تقرير المحاصيل الأمريكي
ثم يقوم بحقن الطفيليات في مجرى الدم عند لدغ أبقار أخرى. بعد ذلك، تغزو طفيليات البابيزيا خلايا الدم الحمراء، حيث تتكاثر عن طريق الانشطار الثنائي. وتؤدي في النهاية إلى تمزق هذه الخلايا.
يؤدي التكاثر المستمر للطفيليات إلى انفجار خلايا الدم الحمراء، ما يسبب فقر الدم الحاد وإطلاق الهيموجلوبين الحر في الدم.
العلامات السريرية
بعد لدغة القراد المصاب، تتراوح فترة حضانة البابيزيا بين 2 إلى 3 أسابيع، مما يؤدي إلى ظهور أشكال مختلفة من المرض: الشكل فوق الحاد، الحاد، المزمن، وغير الظاهر.
الشكل فوق الحاد:
يتميز بمرض شديد يؤدي إلى الوفاة خلال 3 إلى 7 أيام، وغالبًا يكون السبب الصدمة.
الشكل الحاد :
| بول مدمم |
- تبدأ الأعراض الحادة بارتفاع درجة الحرارة (41-42 درجة مئوية)
وتتميز بالتوعك، فقدان الشهية، الإمساك الذي يليه الإسهال،
– زيادة معدل التنفس ونبض القلب، احتمالية الإجهاض في الحيوانات الحوامل، وقد يحدث العقم المؤقت بسبب الحمى في الثيران ووجود البول الأحمر .
الشكل المزمن:
- يتميز بالهزال، فقر الدم، اليرقان، التورم،
| شحوب الأغشية المخاطية |
- اضطرابات الجهاز العصبي المركزي قد تحدث أيضًا، وتشمل فقدان التنسيق الحركي، تصلب المشية، التشنجات والغيبوبة.
- انخفاض انتاج الحليب ومعدل التحول الغذائى.
- تكون معدلات الوفيات مرتفعة في الأشكال الحادة وتحت الحادة من المرض.
الصفة التشريحية لمرض البابيزيا في الأبقار:
تضخم الطحال ، شحوب العضلات، اليرقان، تضخم الكلى الداكنة،
نزيف كبدي تحت الجلد و قد يكون الكبد متضخمًا ولونه أصفر.
التشخيص :
- وجود القراد على الحيوانات المصابة.
- الأعراض السريرية.
-
B.bigeminanaa B.bovis فحص مسحات الدم تحت المجهر.
- استخدام اختبارات الأجسام المضادة، مثل الإختبار غير المباشر للأجسام المضادة الفلورية (IFAT) أو الإختبار المناعي المرتبط بالإنزيم (ELISA) لتحديد العدوى السابقة وانتشار المرض.
- التشخيص الجزيئي باستخدام تقنية PCR .
مكافحة مرض البابيزيا:
- عزل الحيوانات المصابة وعلاجها لمنع انتشار العدوى.
- السيطرة على القراد من خلال رش الحيوانات بمبيدات القراد المناسبة على فترات منتظمة.
- العلاج المناعي الكيميائي: من خلال الإعطاء المتزامن لعقار إيميدوكارب .
علاج مرض البابيزيا في الأبقار:
- إيميدوكارب (Imizol) عن طريق الحقن العضلي أو تحت الجلد بجرعة 2 مللي/100 كجم من وزن الحيوان أو ديمينازين أسيتورات (Berenil) ، يُحقن عضليًا بجرعة 3-5 ملجم/كجم.
- في الحالات الشديدة يوصى بنقل الدم واستخدام العوامل المضادة للالتهابات.
- حقن بالوريد محلول جلوكوز مع أملاح معدنية وفيتامينات لتعويض الحديد والنحاس والكوبالت و فيتامين ب المركب.
- رش المكان والمزرعة بالمبيد الحشرى لمكافحة القراد.
تابع التطورات الإضافية للوضع في سوق الحبوب على موقعنا.
المراجع:
Chandran,D. (2021): Bovine babesiosis: A general review, International Journal of Veterinary Sciences and Animal Husbandry; 6(3): 40-44 DOI: https://doi.org/10.22271/veterinary.2021.v6.i3a.359
Mwato, M. (2023): Bovine babesiosis in cattle: Causes, symptoms, diagnosis, and treatment. Bivatec Ltd. Retrieved February 20, 2025, from https://www.bivatec.com/blog/bovine-babesiosis-in-cattle.